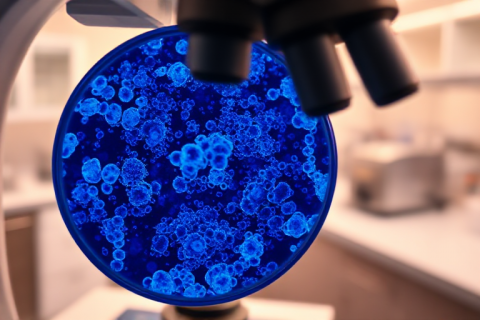

Autonomous Trucks to Hit European Roads by 2027: Exclusive Report The Advanced Clean Transportation (ACT) show attracted 12,000 attendees...
Archive for month: May, 2025
Exclusive: OpenAI Unveils Plan for ChatGPT Super Assistant
, AI VALUE POTENTIAL, ENTERPRISE INTEGRATIONHIGHLIGHTS OpenAI is poised to revolutionize AI capabilities by transforming ChatGPT into a cutting-edge tool. The ultimate goal is...
Exclusive: Autonomous Trucks Roll Out by 2027, Revolutionizing Long-Haul Ops
, ENTERPRISE INTEGRATION, REQUIRED CAPABILITIESHIGHLIGHTS Innovative transportation solutions were showcased at the recent Advanced Clean Transportation (ACT) conference, highlighting the latest advancements in...
Breaking News: AI Predicts Prostate Cancer Treatment Success with Unprecedented Accuracy
, AI VALUE POTENTIAL, COMPANY/PRODUCT NEWSHIGHLIGHTS A team of international researchers has designed an AI-powered diagnostic tool that can accurately predict which men with...
Google’s AI Overviews: 1 Billion Users Misled by Hallucinations
, OVERCOMING CHALLENGES, REQUIRED CAPABILITIESHIGHLIGHTS The AI Overviews feature has been plagued by inaccuracies, including hallucinations and absurdly wrong answers. The issue’s scope...
Nvidia’s AI Demand Soars, US Trade Restrictions Hit Hard
, COMPANY/PRODUCT NEWS, REQUIRED CAPABILITIESHIGHLIGHTS Nvidia’s quarterly revenue surges 69% to $44.1 billion, driven by strong demand for its data center solutions. The...
2025-05-30: Breakthroughs in AI Revolutionize Logistics & Media Industry, Unlocking Insights and Transforming the Future
, DAILY SUMMARY$11 Trillion at Stake: Vertical LLMs Revolutionize Global Logistics The distinction between general-purpose large language models (LLMs) and vertical...
Salesforce Unveils CRMArena-Pro: AI Agent Readiness Benchmark
, AI VALUE POTENTIAL, ENTERPRISE INTEGRATIONHIGHLIGHTS A novel evaluation framework is being designed to assess AI agents’ capabilities in real-world scenarios. Current benchmarks fall...
Breaking News: NVIDIA-Powered Doudna Supercomputer Unveiled
, COMPANY/PRODUCT NEWS, ENTERPRISE INTEGRATIONHIGHLIGHTS A new supercomputer, Doudna, is set to revolutionize scientific research at Lawrence Berkeley National Laboratory in 2026. Doudna...
Breaking News: AI-Powered SOC Defeats DanaBot, Cuts Analysis Time
, ENTERPRISE INTEGRATION, OVERCOMING CHALLENGESThis article is a summary/commentary to the article from Louis Columbus, 2025-05-29, DanaBot takedown shows how agentic AI cut...
Recent Posts
- 2026-03-28: AI-Powered Innovations Transform Industries and Lives by 2026
- AI’s Future Put to the Test: Top Execs Sound Alarm
- Innovative Eyewear Leads 2026 Smart Safety Glasses Market on Amazon
- 2026-03-27: AI Industry Experiences Turbulence Amidst Innovation and Investment
- OpenAI Shelves Controversial “Adult Mode” Amid Safety, Brand Fears